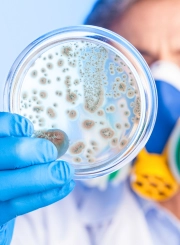
Total Coliform Testing water

Bacteria in Water Testing
Science Research & Verify Laboratory Services For Water Testing
- DOH / DEP / EPA / NELAP Standards
- Residential & Commercial
- HPC - Heterotrophic Plate Count
- E. coli
- Total Coliform
Industries We Serve
On Site
Bacteria in
Water Testing

Residential E. coli Water Testing
✔️ Protect home water from E. coli
✔️ Accurate, EPA-approved detection
✔️ Ideal for homes and apartments
✔️ Quick results for family safety

Commercial E. coli Water Testing
✔️ Safe water for businesses
✔️ Comprehensive E. coli testing
✔️ Health department compliance
✔️ Expert risk management support

Heterotrophic Plate Count Testing
✔️ Measure overall bacterial load
✔️ Assess general water quality
✔️ Useful for all water systems
✔️ Supports proactive maintenance
Total Coliform Testing
✔️ Detect total coliform bacteria
✔️ Crucial for water quality in all settings
✔️ EPA-approved accuracy
✔️ Early detection of health risks
Industries We Serve
On Site
Bacteria in
Water Testing

Schools & Daycare
License Recertification
✔️ Lead in drinking water via method EPA 200.8
✔️ Copper in drinking water via method EPA 200.8
✔️ Mitigation & risk management support
✔️ Health department regulatory compliant
✔️ Remove your violations today

Chemicals
PFAS, VOCs, HAA5 & More
✔️ PFAS analysis via EPA methods 533 and 537.1
✔️ VOC's analysis via 524.2
✔️ HAA5, a disinfection byproduct
✔️ Need specific chemical parameters?
✔️ Reach out to our client services team 24 x 7

Residential & Commercial
Water Potability
1. Infrastructure contamination is a leading concern
2. Heavy metals are some of the biggest contaminants facing NYC
3. Copper plumbing prior to 1988 is soldered with LEAD
✔️ Apartment buildings
✔️ Office buildings
✔️ Condos and co-op's
✔️ Food establishments
✔️ Hotels
✔️ Nursing homes

Lead and
Copper
1. There is NO safe level of lead
2. Lead = <15 ug/l per EPA
3. Copper = < 1300 ug/l per EPA
✔️ Regulatory analysis via EPA Method 200.8
✔️ Our experts offer advice on mitigation and risk management
✔️ comply with Health Department regulations

Colilert - E. Coli +
Total Coliform
✔️ Colilert: Detection and enumeration of total coliforms & Escherichia coli via EPA Method SM 20, 21-23 9223B
✔️ Heterotrophic Plate Count (HPC): Estimated total number of viable microorganisms

Microplastic Analysis
in Drinking Water
✔️ Plastics Count with Identification by Raman Spectrometry
✔️ Particle Size Analysis by Microplastics Identification
Range: 5mm to 1um

Legionella
Bacteria
✔️ Everyone should test
✔️ Thrives in water tanks
✔️ Multiplies in hot water systems
✔️ Cooling towers are a risk factor
✔️ We offer point of use testing

Pools, Spas and
Hot Tubs
✔️ Discolored water investigations
✔️ Colilert bacteria sampling
✔️ Weekly and monthly service
✔️ We abide by all regulatory requirements
What People Say
Is Your Water Contaminated with Bacteria?
- More Than 10,000 Clients Served*
- More Than 500,000 People Protected*
Work with the Most Reliable Water Testing Company for E. Coli and Total Coliform Bacteria Testing in NYC, NJ and CT
At Olympian Water Testing™, we provide our residential and commercial clients with tailored bacteria in water testing. Many of our clients contact us to have their swimming pools, spas, and food businesses tested for E Coli and total coliform due to both regulatory requirements and diligence.
There are a few reasons you might need to test your water for bacteria:
- You are concerned about your water quality
- You are experiencing poor water quality
- It is time to test your water to stay in compliance with city and state regulations
Whatever the reason, you can trust the experts at Olympian Water Testing™. Our lab specialists will come out and professionally collect water samples from your location. We will courier your samples on ice back to our designated NELAP-certified laboratory to test the water for bacteria.
Call Olympian Water Testing™ to schedule your appointment for bacteria in water testing services.
Why Choose Olympian™ for Bacteria Water Testing

Qualified
Staff
Our E. coli and Total Coliform water testing is carried out by fully qualified and experienced technicians - all of whom are experts in their field.

Quality and Control
All our testing is conducted through our National Environmental Laboratory Accreditation Program (NELAP) certified New York and New Jersey State Laboratories.

Collect Water Samples
We will professionally collect samples from your water sources to regulatory standards and have our NELAP certified laboratory team partners process and analyze them.

State of the Art Facilities
Utilizing Only high end, accurate and top-of-the-line Laboratories allow us to turn results around quickly and efficiently with a variety of our most popular key tests and analyses.

Unmatched
Expertise
Having been in business since 1991 in the Greater New York City Area, we definitely know a thing or two about the drinkability of New York and New Jersey water!
Do You Have Bacteria in Your Water?
FAQs
Bacteria In Water
Testing
Water potability – also known as potable drinking water testing and focuses on bacteria testing, or coliform bacteria testing – which is an integral part of guaranteeing the quality of the water supply. It is most commonly used to test commercial and residential water in municipal systems, community areas, and even household and agricultural wells. It is primarily used to test for heavy metals and bacterial contamination sources that frequently occur in drinking water due to the nature of plumbing systems.
Access to safe drinking water is essential to health, a basic human right, and part of an effective policy for health protection. In some regions, investments in water supply and sanitation can even bring economic benefits due to the reductions in adverse health effects and healthcare costs. Know what’s in your drinking water and be proactive in maintaining high water quality standards in your home or business setting.
Drinking water is safe and within the normal standards set by city regulations and the EPA when it leaves the treatment plant. However, water can get contaminated after it leaves the plant. Contamination typically happens due to failures in the system, after major storms and during power outages It also often occurs in recreational water due to human waste contamination.
Our testing will check for bacteria cover E. coli and total coliform per standard protocol. Certain facilities require their water to be tested every week such as the NYC department of parks and recreation, professional health clubs. And others opt for service once a month. Our staff is familiar with local rules and regulations, ensuring your testing and analysis keep you, your company and your team in compliance.
Olympian Water Testing serves Brooklyn, Queens, Manhattan, the Bronx, Staten Island, Manhattan, Nassau County, Yonkers, Westchester, and the entire NYC region.
Olympian Water testing Provides On Site Professional Regulatory Water Testing Throughout Paterson, Newark, Elizabeth, Union, Jersey City, North Bergen, Bayonne, Woodbridge, New Brunswick, Secaucus, Hoboken, Kearny, West New York, Edison, Plainfield and most surrounding New Jersey areas.
Olympian Water Testing provides on-site professional regulatory water testing throughout Hartford, Stamford, Bridgeport, New Haven, Waterbury, Danbury, Norwalk, Meriden, Fairfield, New London, West Haven, Manchester, East Haven, New Britain, and most surrounding Connecticut areas.
Contact Client Services
- ONLINE NOW







